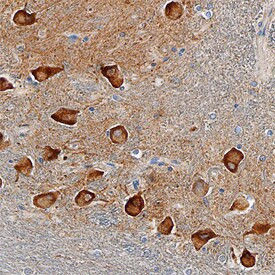
SorCS2 Antibody in Immunohistochemistry (Paraffin) (IHC (P))

Search
Invitrogen
SorCS2 Polyclonal Antibody
{{$productOrderCtrl.translations['antibody.pdp.commerceCard.promotion.promotions']}}
{{$productOrderCtrl.translations['antibody.pdp.commerceCard.promotion.viewpromo']}}
{{$productOrderCtrl.translations['antibody.pdp.commerceCard.promotion.promocode']}}: {{promo.promoCode}} {{promo.promoTitle}} {{promo.promoDescription}}. {{$productOrderCtrl.translations['antibody.pdp.commerceCard.promotion.learnmore']}}
图: 1 / 2
SorCS2 Antibody (PA5-47597) in IHC (P)


Please note: We are reviewing Western blot images included in the antibody testing data in our catalog, including those provided by third parties. Unless expressly labeled or annotated as “raw-unedited”, Western blot images included in the antibody testing data in our catalog may have been edited, optimized or otherwise adjusted for presentation.
产品信息
PA5-47597
种属反应
宿主/亚型
分类
类型
抗原
偶联物
形式
浓度
规格
纯化类型
保存液
内含物
保存条件
运输条件
RRID
产品详细信息
In direct ELISAs and Western blots, approximately 20% cross-reactivity with recombinant mouse (rm) SorCS2 is observed and less than 1% cross-reactivity with recombinant human (rh) SorCS1 and rhSorCS3 is observed.
Reconstitute at 0.2 mg/mL in sterile PBS.
靶标信息
This gene encodes one family member of vacuolar protein sorting 10 (VPS10) domain-containing receptor proteins. The VPS10 domain name comes from the yeast carboxypeptidase Y sorting receptor Vps10 protein. Members of this gene family are large with many exons but the CDS lengths are usually less than 3700 nt. Very large introns typically separate the exons encoding the VPS10 domain; the remaining exons are separated by much smaller-sized introns. These genes are strongly expressed in the central nervous system.
仅用于科研。不用于诊断过程。未经明确授权不得转售。